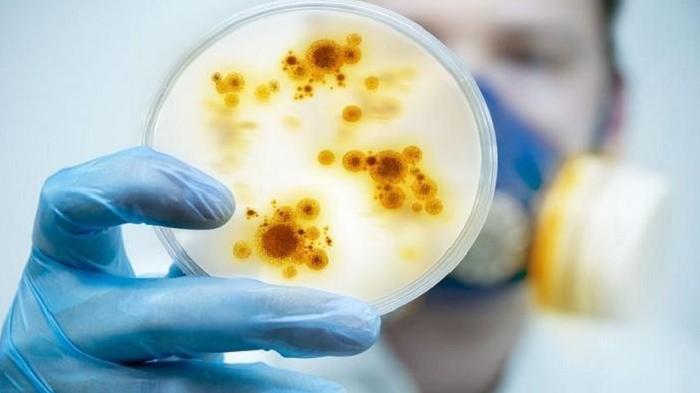

TRIBUNJUALBELI.COM - Bersih-bersih rumah memang tak sekadar membuat barang-barang terlihat bersih, namun juga seharusnya bebas kuman.
Fakta membuktikan, ada banyak barang di rumah yang ternyata ketika diteliti mengandung bakteri yang jumlahnya bikin ngeri.
Pengin tahu?
Hasil surve yang dilakukan oleh Hygiene Councilini, Amerika ini mungkin tak pernah kamu duga.
Begitu banyak kuman mengintai di rumah.
BACA JUGA : Jarang Ganti Handuk Mandi Bisa Jadi Sarang Bakteri, Namun Ini Bisa Jadi Solusinya
BACA JUGA : Sering Jadi Sarang Virus dan Bakteri, Segera Bersihkan 8 Benda Ini
Inilah datanya.
1. Remote control: 70 bakteri/inci persegi
2. Sink dapur: 17.964 bakteri/inci persegi
3. Pegangan keran di dapur: 13.227 bakteri/inci persegi
4. Busa cuci dan lap dapur: 134.630 bakteri/inci persegi
5. Lantai dapur di depan sink: 830 bakteri/inci persegi
6. Rak dapur: 488 bakteri/inci persegi
7. Tempat sampah: 411 bakteri/inci persegi
8. Kulkas (bagian pintunya); 319 bakteri/inci
9. Lap piring: 408 bakteri/inci persegi
10. Talenan: 94 bakteri/inci persegi
11. Wastafel: 567.845 bakteri/inci persegi
12. Toilet (mangkuk/bowl: 3,2 juta bakteri/inci persegi; dudukan:295 bakteri/inci persegi; flush: 83 bakteri/ inci persegi
13. Bak mandi, bathtub (bagian yang dekat pembuangan air): 119.468 bakteri/inci persegi
14. Lantai (di depan toilet): 764 bakteri/inci persegi
15. Pegangan pintu kamar mandi: 6.267 bakteri/inci persegi
16. Tombol lampu kamar mandi: 217 bakteri/inci persegi
17. Mainan: 345 bakteri/inci persegi
18. Telepon dan handphone: 319 bakteri/inci persegi
19. Keyboard komputer: 64 bakteri/inci persegi. (*)
(Andrakp/Tribunjualbeli.com)

Belum ada komentar. Jadilah yang pertama untuk memberikan komentar!